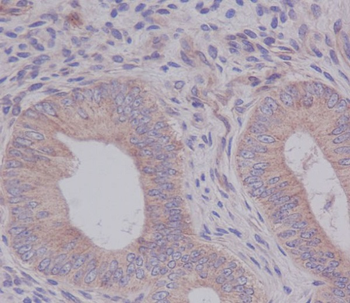
eIF5A Rabbit mAb

You have no items in your shopping cart.
You have no items in your shopping cart.
| Catalog Number | orb1951582 |
|---|---|
| Category | Antibodies |
| Description | eIF5A Rabbit mAb |
| Clonality | Recombinant |
| Species/Host | Rabbit |
| Conjugation | Unconjugated |
| Reactivity | Human, Mouse, Rat |
| UniProt ID | P63241 |
| Tested applications | FC, ICC, IHC, IP, WB |
| Antibody Type | Recombinant Antibody |
| Storage | Maintain refrigerated at 2-8°C for up to 2 weeks. For long term storage store at -20°C in small aliquots to prevent freeze-thaw cycles. |
| Note | For research use only |

Immunofluorescent analysis of Hela cells, using eIF5A Antibody.
Immunohistochemical analysis of paraffin-embedded human uterus cancer, using eIF5A Antibody.

Western blot analysis of eIF5A expression in Jurkat cell lysate.
IHC-P, IP, WB | |
Human, Mouse, Rat | |
Monoclonal | |
Unconjugated |
FC, ICC, IHC, IP, WB | |
Human, Mouse, Rat | |
Rabbit | |
Recombinant | |
Unconjugated |
Participating in our Biorbyt product reviews program enables you to support fellow scientists by sharing your firsthand experience with our products.
Login to Submit a Review